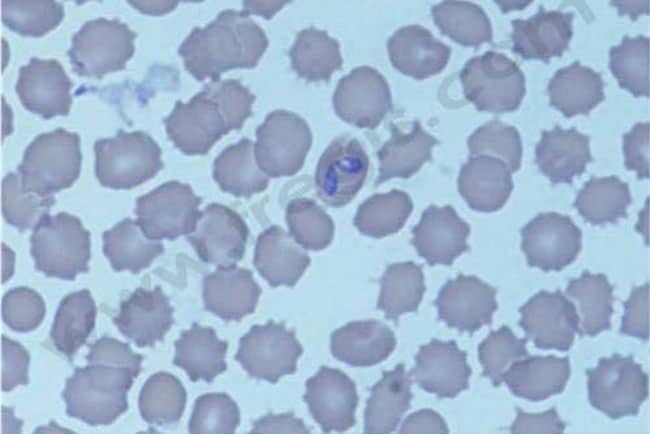

Les
signes cliniques sont principalement liés au manque de globules rouges et donc d’oxygène dans les différents tissus, mais également au processus de destruction des globules rouges et au phénomène d’inflammation généralisée. Les propriétaires décrivent souvent : faiblesse, intolérance à l’exercice,
abattement,
collapsus, respiration rapide, difficultés respiratoires,
vomissements, diarrhée, parfois l’augmentation de la prise de boisson et de l’émission d’urine. L’
examen clinique révèle typiquement : muqueuses pâles, respiration rapide,
rate et/ou foie de taille augmentée,
jaunisse, urines foncées,
fièvre et ganglions augmentés de taille, battements cardiaques rapides, rythme de galop et
souffle cardiaque. Des signes cliniques rares sont l’anémie et la
nécrose des extrémités lors de temps froid. Certains chiens avec une AHMI ont une destruction des
plaquettes sanguines (
thrombocytopénie) concomitante connue en tant que
syndrome d’Evans et peuvent également présenter des saignements au niveau des muqueuses (gencives,…) ou autres (sang dans l’urine,…).